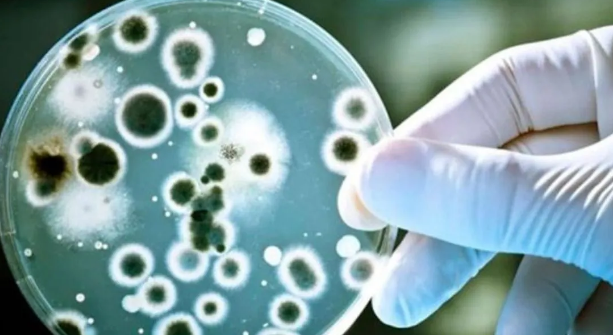

Cecilia: marcharon para pedir que los Sena no tengan prisión domiciliaria
Gloria Romero, mamá de Cecilia Strzyzowski, encabezó una manifestación frente a la fiscalía en Chaco para que se le niegue la prisión domici
Gloria Romero, mamá de Cecilia Strzyzowski, pidió esta tarde al encabezar una manifestación frente a la fiscalía de la capital provincial que se le niegue la prisión domiciliaria por temas médicos a los suegros de la víctima, quienes son dos de los siete detenidos que hay en la causa por el femicidio de la joven.
"Esta fue una marcha improvisada por el tema que se está pidiendo la domiciliaria. Al no tener historia clínica, están pidiendo una junta médica. Y también me enteré que querían visitas higiénicas Marcela Acuña (51) con Emerenciano Sena (59)", expresó Gloria en diálogo con el canal de noticias Crónica TV, rodeada de los casi 400 manifestantes que la acompañaron frente a las oficinas del Ministerio Público chaqueño.
La convocatoria comenzó a partir de las 16 en la puerta de la sede judicial de la calle 9 de Julio 236, donde los presentes portaban globos rosas y pancartas que decían "Justicia por Cecilia" y "Perpetua para los culpables".
Gloria, que vestía una remera de la Selección argentina de fútbol y una gorra con la imagen de su hija, dijo estar "preocupada" ante la carta que presentó Acuña el pasado 3 de julio, donde la mujer manifestó desde la cárcel que ella y su esposo están detenidos "siendo inocentes" en una causa "armada por el partido judicial y radicales".

"Lo que más me preocupa de esa carta es que se está cumpliendo y el circo que están haciendo para darles la domiciliaria. Cuando hay plata se puede hacer todo...La presión social es lo que está manteniendo que esto se cumpla", opinó Romero.
Además, la mamá de Cecilia agradeció el apoyo recibido por los manifestantes, a la vez que señaló que "todavía no se sabe nada" de su hija.
Seguimos con el tema del ADN que demora 30 días. Si Emerenciano sale a la calle, mi vida ya no vale nada. Yo soy kamikaze y estoy jugada. Si ellos están libres, me debería ir del país", cerró.